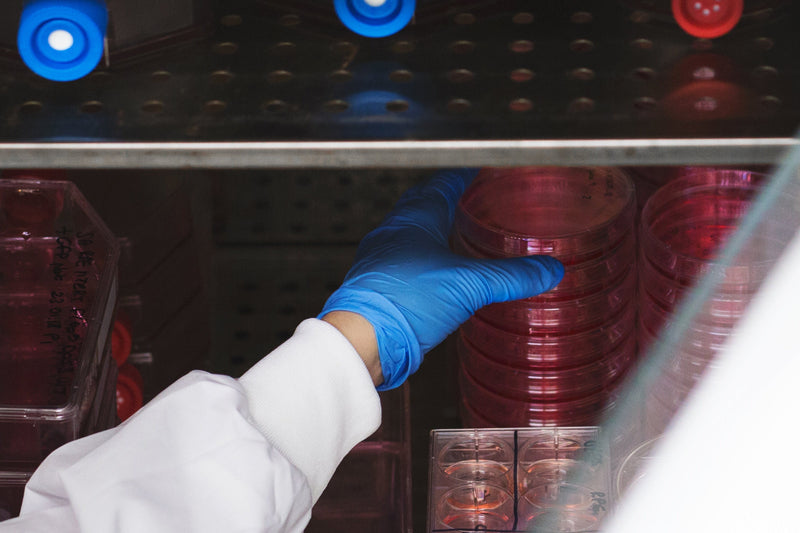
Person wearing a white lab coat and blue gloves handling red containers in a laboratory setting.

Custom Reagents & Formulations
Sale price£0.00
Third Party Quality Control Services
Sale price£0.00
Contract Product Development
Sale price£0.00
Reference Lab Services
Sale price£0.00
Technical Support Solutions
Sale price£0.00
Tailored Support Services
Sale price£0.00